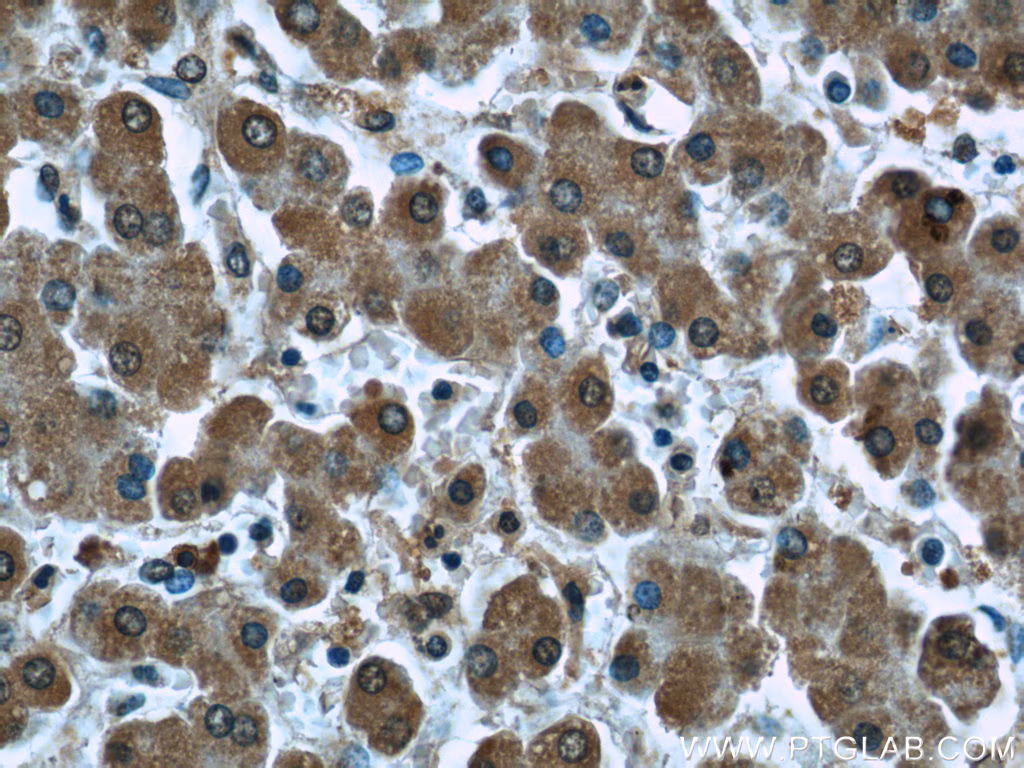
Immunohistochemical analysis of paraffin-embedded human liver tissue slide using 66119-1-Ig (PDH E1α antibody at dilution of 1:50(under 40x lens).

Validation Data Gallery
Various lysates were subjected to SDS PAGE followed by western blot with 82957-2-RR (FDX1 antibody) at dilution of 1:3000 incubated at room temperature for 1.5 hours.
× Various lysates were subjected to SDS PAGE followed by western blot with 82957-2-RR (FDX1 antibody) at dilution of 1:3000 incubated at room temperature for 1.5 hours.
![]()
Various lysates were subjected to SDS PAGE followed by western blot with 83654-3-RR (DLAT antibody) at dilution of 1:10000 incubated at room temperature for 1.5 hours.
× Various lysates were subjected to SDS PAGE followed by western blot with 83654-3-RR (DLAT antibody) at dilution of 1:10000 incubated at room temperature for 1.5 hours.
![]()
Various lysates were subjected to SDS PAGE followed by western blot with 67298-1-Ig (LIAS antibody) at dilution of 1:3000 incubated at room temperature for 1.5 hours.
× Various lysates were subjected to SDS PAGE followed by western blot with 67298-1-Ig (LIAS antibody) at dilution of 1:3000 incubated at room temperature for 1.5 hours.
![]()
HepG2 cells were subjected to SDS PAGE followed by western blot with 67221-1-Ig (SLC31A1 antibody) at dilution of 1:20000 incubated at room temperature for 1.5 hours.
× HepG2 cells were subjected to SDS PAGE followed by western blot with 67221-1-Ig (SLC31A1 antibody) at dilution of 1:20000 incubated at room temperature for 1.5 hours.
![]()
Various lysates were subjected to SDS PAGE followed by western blot with 67702-1-Ig (DLD antibody) at dilution of 1:5000 incubated at room temperature for 1.5 hours.
× Various lysates were subjected to SDS PAGE followed by western blot with 67702-1-Ig (DLD antibody) at dilution of 1:5000 incubated at room temperature for 1.5 hours.
![]()
Various lysates were subjected to SDS PAGE followed by western blot with 68238-1-Ig (PDHB antibody) at dilution of 1:10000 incubated at room temperature for 1.5 hours.
× Various lysates were subjected to SDS PAGE followed by western blot with 68238-1-Ig (PDHB antibody) at dilution of 1:10000 incubated at room temperature for 1.5 hours.
![]()
HepG2 cells were subjected to SDS PAGE followed by western blot with 66119-1-Ig (PDH E1α antibody) at dilution of 1:20000 incubated at room temperature for 1.5 hours.
× HepG2 cells were subjected to SDS PAGE followed by western blot with 66119-1-Ig (PDH E1α antibody) at dilution of 1:20000 incubated at room temperature for 1.5 hours.
![]()
Various lysates were subjected to SDS PAGE followed by western blot with 85288-2-RR (ATP7B-Specific antibody) at dilution of 1:10000 incubated at room temperature for 1.5 hours.
× Various lysates were subjected to SDS PAGE followed by western blot with 85288-2-RR (ATP7B-Specific antibody) at dilution of 1:10000 incubated at room temperature for 1.5 hours.
![]()
HEK-293 cells were subjected to SDS PAGE followed by western blot with 83012-5-RR (GCSH antibody) at dilution of 1:10000 incubated at room temperature for 1.5 hours.
× HEK-293 cells were subjected to SDS PAGE followed by western blot with 83012-5-RR (GCSH antibody) at dilution of 1:10000 incubated at room temperature for 1.5 hours.
![]()
Various lysates were subjected to SDS PAGE followed by western blot with 12451-1-AP (DBT antibody) at dilution of 1:15000 incubated at room temperature for 1.5 hours.
× Various lysates were subjected to SDS PAGE followed by western blot with 12451-1-AP (DBT antibody) at dilution of 1:15000 incubated at room temperature for 1.5 hours.
![]()
Various lysates were subjected to SDS PAGE followed by western blot with 81486-1-RR (GLS antibody) at dilution of 1:10000 incubated at room temperature for 1.5 hours.
× Various lysates were subjected to SDS PAGE followed by western blot with 81486-1-RR (GLS antibody) at dilution of 1:10000 incubated at room temperature for 1.5 hours.
![]()
IP result of anti-PDH E1 Alpha (IP:66119-1-Ig, 4ug; Detection:66119-1-Ig 1:10000) with K-562 cells lysate 1820 ug.
× IP result of anti-PDH E1 Alpha (IP:66119-1-Ig, 4ug; Detection:66119-1-Ig 1:10000) with K-562 cells lysate 1820 ug.
![]()
Immunohistochemical analysis of paraffin-embedded human stomach cancer tissue slide using 82957-2-RR (FDX1 antibody) at dilution of 1:400 (under 20x lens). Heat mediated antigen retrieval with Tris-EDTA buffer(pH9).
× Immunohistochemical analysis of paraffin-embedded human stomach cancer tissue slide using 82957-2-RR (FDX1 antibody) at dilution of 1:400 (under 20x lens). Heat mediated antigen retrieval with Tris-EDTA buffer(pH9).
![]()
Immunohistochemical analysis of paraffin-embedded human stomach cancer tissue slide using 83654-3-RR (DLAT antibody) at dilution of 1:500 (under 20x lens). Heat mediated antigen retrieval with Tris-EDTA buffer(pH9).
× Immunohistochemical analysis of paraffin-embedded human stomach cancer tissue slide using 83654-3-RR (DLAT antibody) at dilution of 1:500 (under 20x lens). Heat mediated antigen retrieval with Tris-EDTA buffer(pH9).
![]()
Immunohistochemical analysis of paraffin-embedded mouse brain tissue slide using 67298-1-Ig (LIAS antibody) at dilution of 1:1000 (under 10x lens). Heat mediated antigen retrieval with Tris-EDTA buffer (pH 9.0).
× Immunohistochemical analysis of paraffin-embedded mouse brain tissue slide using 67298-1-Ig (LIAS antibody) at dilution of 1:1000 (under 10x lens). Heat mediated antigen retrieval with Tris-EDTA buffer (pH 9.0).
![]()
Immunohistochemical analysis of paraffin-embedded human liver cancer tissue slide using 67221-1-Ig (SLC31A1 antibody) at dilution of 1:2000 (under 40x lens). Heat mediated antigen retrieval with Tris-EDTA buffer (pH 9.0).
× Immunohistochemical analysis of paraffin-embedded human liver cancer tissue slide using 67221-1-Ig (SLC31A1 antibody) at dilution of 1:2000 (under 40x lens). Heat mediated antigen retrieval with Tris-EDTA buffer (pH 9.0).
![]()
Immunohistochemical analysis of paraffin-embedded human liver cancer tissue slide using 67702-1-Ig (DLD antibody) at dilution of 1:500 (under 10x lens). Heat mediated antigen retrieval with Tris-EDTA buffer (pH 9.0).
× Immunohistochemical analysis of paraffin-embedded human liver cancer tissue slide using 67702-1-Ig (DLD antibody) at dilution of 1:500 (under 10x lens). Heat mediated antigen retrieval with Tris-EDTA buffer (pH 9.0).
![]()
Immunohistochemical analysis of paraffin-embedded mouse kidney tissue slide using 68238-1-Ig (PDHB antibody) at dilution of 1:1000 (under 40x lens). Heat mediated antigen retrieval with Tris-EDTA buffer (pH 9.0).
× Immunohistochemical analysis of paraffin-embedded mouse kidney tissue slide using 68238-1-Ig (PDHB antibody) at dilution of 1:1000 (under 40x lens). Heat mediated antigen retrieval with Tris-EDTA buffer (pH 9.0).
![]()
Immunohistochemical analysis of paraffin-embedded human liver tissue slide using 66119-1-Ig (PDH E1α antibody at dilution of 1:50(under 40x lens).
× Immunohistochemical analysis of paraffin-embedded human liver tissue slide using 66119-1-Ig (PDH E1α antibody at dilution of 1:50(under 40x lens).
![]()
Immunohistochemical analysis of paraffin-embedded mouse liver tissue slide using 85288-2-RR (ATP7B-Specific antibody) at dilution of 1:2000 (under 40x lens). Heat mediated antigen retrieval with Tris-EDTA buffer (pH 9.0).
× Immunohistochemical analysis of paraffin-embedded mouse liver tissue slide using 85288-2-RR (ATP7B-Specific antibody) at dilution of 1:2000 (under 40x lens). Heat mediated antigen retrieval with Tris-EDTA buffer (pH 9.0).
![]()
Immunohistochemical analysis of paraffin-embedded human stomach cancer tissue slide using 12451-1-AP (DBT antibody) at dilution of 1:1000 (under 10x lens). Heat mediated antigen retrieval with Tris-EDTA buffer (pH 9.0).
× Immunohistochemical analysis of paraffin-embedded human stomach cancer tissue slide using 12451-1-AP (DBT antibody) at dilution of 1:1000 (under 10x lens). Heat mediated antigen retrieval with Tris-EDTA buffer (pH 9.0).
![]()
Immunohistochemical analysis of paraffin-embedded mouse brain tissue slide using 81486-1-RR (GLS antibody) at dilution of 1:400 (under 40x lens). Heat mediated antigen retrieval with Tris-EDTA buffer (pH 9.0).
× Immunohistochemical analysis of paraffin-embedded mouse brain tissue slide using 81486-1-RR (GLS antibody) at dilution of 1:400 (under 40x lens). Heat mediated antigen retrieval with Tris-EDTA buffer (pH 9.0).
![]()
Immunofluorescent analysis of (4% PFA) fixed HepG2 cells using FDX1 antibody (82957-2-RR, Clone: 230196E9 ) at dilution of 1:400 and CoraLite®488-Conjugated Goat Anti-Rabbit IgG(H+L) (SA00013-2), CL594-Phalloidin (red).
× Immunofluorescent analysis of (4% PFA) fixed HepG2 cells using FDX1 antibody (82957-2-RR, Clone: 230196E9 ) at dilution of 1:400 and CoraLite®488-Conjugated Goat Anti-Rabbit IgG(H+L) (SA00013-2), CL594-Phalloidin (red).
![]()
Immunofluorescent analysis of (4% PFA) fixed HepG2 cells using DLAT antibody (83654-3-RR, Clone: 240713C12 ) at dilution of 1:250 and CoraLite®488-Conjugated AffiniPure Goat Anti-Rabbit IgG(H+L) (SA00013-2), CL594-Phalloidin (red).
× Immunofluorescent analysis of (4% PFA) fixed HepG2 cells using DLAT antibody (83654-3-RR, Clone: 240713C12 ) at dilution of 1:250 and CoraLite®488-Conjugated AffiniPure Goat Anti-Rabbit IgG(H+L) (SA00013-2), CL594-Phalloidin (red).
![]()
Immunofluorescent analysis of (4% PFA) fixed human liver cancer tissue using 67221-1-Ig (SLC31A1 antibody) at dilution of 1:100 and CoraLite488-Conjugated AffiniPure Goat Anti-Mouse IgG(H+L).
× Immunofluorescent analysis of (4% PFA) fixed human liver cancer tissue using 67221-1-Ig (SLC31A1 antibody) at dilution of 1:100 and CoraLite488-Conjugated AffiniPure Goat Anti-Mouse IgG(H+L).
![]()
Immunofluorescent analysis of (4% PFA) fixed HeLa cells using PDHB antibody (68238-1-Ig, Clone: 2A7C10 ) at dilution of 1:1000 and Multi-rAb CoraLite® Plus 594-Goat Anti-Mouse Recombinant Secondary Antibody (H+L) (Cat.NO. RGAM004 ).
× Immunofluorescent analysis of (4% PFA) fixed HeLa cells using PDHB antibody (68238-1-Ig, Clone: 2A7C10 ) at dilution of 1:1000 and Multi-rAb CoraLite® Plus 594-Goat Anti-Mouse Recombinant Secondary Antibody (H+L) (Cat.NO. RGAM004 ).
![]()
Immunofluorescent analysis of HepG2 cells using 66119-1-Ig (PDH E1α antibody) at dilution of 1:100 and Rhodamine-Goat anti-Mouse IgG.
× Immunofluorescent analysis of HepG2 cells using 66119-1-Ig (PDH E1α antibody) at dilution of 1:100 and Rhodamine-Goat anti-Mouse IgG.
![]()
Immunofluorescent analysis of (4% PFA) fixed paraffin-embedded mouse liver tissue using ATP7B-Specific antibody (85288-2-RR, Clone: 242827B3 ) at dilution of 1:400 and CoraLite®488-Conjugated Goat Anti-Rabbit IgG(H+L) (SA00013-2). Heat mediated antigen retrieval with Tris-EDTA buffer (pH 9.0).
× Immunofluorescent analysis of (4% PFA) fixed paraffin-embedded mouse liver tissue using ATP7B-Specific antibody (85288-2-RR, Clone: 242827B3 ) at dilution of 1:400 and CoraLite®488-Conjugated Goat Anti-Rabbit IgG(H+L) (SA00013-2). Heat mediated antigen retrieval with Tris-EDTA buffer (pH 9.0).
![]()
Immunofluorescent analysis of (4% PFA) fixed HepG2 cells using DBT antibody (12451-1-AP) at dilution of 1:400 and CoraLite®488-Conjugated Goat Anti-Rabbit IgG(H+L), CL594-Phalloidin (red).
× Immunofluorescent analysis of (4% PFA) fixed HepG2 cells using DBT antibody (12451-1-AP) at dilution of 1:400 and CoraLite®488-Conjugated Goat Anti-Rabbit IgG(H+L), CL594-Phalloidin (red).
![]()
Immunofluorescent analysis of (4% PFA) fixed paraffin-embedded mouse brain tissue using KGA/GAC antibody (81486-1-RR, Clone: 4C20 ) at dilution of 1:400 and CoraLite®488-Conjugated Goat Anti-Rabbit IgG(H+L) (SA00013-2). Heat mediated antigen retrieval with Tris-EDTA buffer (pH 9.0).
× Immunofluorescent analysis of (4% PFA) fixed paraffin-embedded mouse brain tissue using KGA/GAC antibody (81486-1-RR, Clone: 4C20 ) at dilution of 1:400 and CoraLite®488-Conjugated Goat Anti-Rabbit IgG(H+L) (SA00013-2). Heat mediated antigen retrieval with Tris-EDTA buffer (pH 9.0).
![]()
Immunofluorescent analysis of (-20°C Methanol) fixed A549 cells using GLS antibody (81486-1-RR, Clone: 4C20 ) at dilution of 1:1000 and CoraLite®488-Conjugated AffiniPure Goat Anti-Rabbit IgG(H+L) (SA00013-2).
× Immunofluorescent analysis of (-20°C Methanol) fixed A549 cells using GLS antibody (81486-1-RR, Clone: 4C20 ) at dilution of 1:1000 and CoraLite®488-Conjugated AffiniPure Goat Anti-Rabbit IgG(H+L) (SA00013-2).
![]()
1x10^6 A431 cells were intracellularly stained with 0.4 ug FDX1 Recombinant antibody (82957-2-RR, Clone:230196E9) and CoraLite®488-Conjugated AffiniPure Goat Anti-Rabbit IgG(H+L) (SA00013-2)(red), or 0.4 ug Isotype Control (blue). Cells were fixed with 4% PFA and permeabilized with Flow Cytometry Perm Buffer (PF00011-C).
× 1x10^6 A431 cells were intracellularly stained with 0.4 ug FDX1 Recombinant antibody (82957-2-RR, Clone:230196E9) and CoraLite®488-Conjugated AffiniPure Goat Anti-Rabbit IgG(H+L) (SA00013-2)(red), or 0.4 ug Isotype Control (blue). Cells were fixed with 4% PFA and permeabilized with Flow Cytometry Perm Buffer (PF00011-C).
![]()
1x10^6 HepG2 cells were intracellularly stained with 0.25 ug DLAT Recombinant Antibody (83654-3-RR, Clone:240713C12) and APC-Conjugated AffiniPure Goat Anti-Rabbit IgG(H+L)(red), or 0.25 ug Isotype Control (blue). Cells were fixed with 4% PFA and permeabilized with Flow Cytometry Perm Buffer (PF00011-C).
× 1x10^6 HepG2 cells were intracellularly stained with 0.25 ug DLAT Recombinant Antibody (83654-3-RR, Clone:240713C12) and APC-Conjugated AffiniPure Goat Anti-Rabbit IgG(H+L)(red), or 0.25 ug Isotype Control (blue). Cells were fixed with 4% PFA and permeabilized with Flow Cytometry Perm Buffer (PF00011-C).
![]()
1x10^6 HepG2 cells were intracellularly stained with 0.25 ug ATP7B-Specific Recombinant antibody (85288-2-RR, Clone:242827B3) and CoraLite®488-Conjugated Goat Anti-Rabbit IgG(H+L) (SA00013-2)(red), or 0.25 ug Rabbit IgG Isotype Control RecAb (98136-1-RR, Clone: 240953C9) (blue). Cells were fixed with 4% PFA and permeabilized with Flow Cytometry Perm Buffer (PF00011-C).
× 1x10^6 HepG2 cells were intracellularly stained with 0.25 ug ATP7B-Specific Recombinant antibody (85288-2-RR, Clone:242827B3) and CoraLite®488-Conjugated Goat Anti-Rabbit IgG(H+L) (SA00013-2)(red), or 0.25 ug Rabbit IgG Isotype Control RecAb (98136-1-RR, Clone: 240953C9) (blue). Cells were fixed with 4% PFA and permeabilized with Flow Cytometry Perm Buffer (PF00011-C).
![]()
Product Information
Cuproptosis Expanded Antibody Sampler Kit为研究铜死亡通路中的关键蛋白提供了一种经济有效的工具。对于开始新项目的研究人员、筛选多个潜在目标的研究人员或那些仅仅需要较少体积抗体的研究人员来说是非常适合的。
产品介绍
Cuproptosis Expanded Antibody Sampler Kit包含11个用于研究铜死亡通路中的关键蛋白靶点的抗体。
| Antigen | Catalog No. | Host, clonality | Tested Reactivity | Applications | Volume |
| FDX1 | 82957-2-RR | Rabbit Monoclonal | H | WB, IHC, IF/ICC, FC (Intra) | 20 uL |
| DLAT | 83654-3-RR | Rabbit Monoclonal | H, M, Rt | WB, IHC, IF/ICC, FC (Intra) | 20 uL |
| LIAS | 11577-1-AP | Rabbit Polyclonal | H, M, Rt | WB, IHC, IF, IP | 20 uL |
| SLC31A1 | 67221-1-Ig | Mouse Monoclonal | H | WB, IHC, IF-P | 20 uL |
| DLD | 67702-1-Ig | Mouse Monoclonal | H, M, Rt | WB, IHC | 20 uL |
| PDHB | 68238-1-Ig | Mouse monoclonal | H, M, Rt, Pg, Rb | WB, IHC, IF/ICC | 20 uL |
| PDHA1 | 66119-1-Ig | Mouse Monoclonal | H, M, Rt | WB, IP, IHC, IF/ICC | 20 uL |
| ATP7B | 85288-2-RR | Rabbit Monoclonal | H, M, Rt | WB, IHC, IF-P, FC (Intra) | 20 uL |
| GCSH | 83012-5-RR | Rabbit Monoclonal | H | WB | 20 uL |
| DBT | 12451-1-AP | Rabbit Polyclonal | H, M, Rt | WB, IHC, IF/ICC | 20 uL |
| KGA/GAC | 81486-1-RR | Rabbit Monoclonal | H, M, Rt | WB, IHC, IF-P, IF/ICC | 20 uL |
如果此试剂盒中的抗体不满足您的需求,请参考我们的Cuproptosis Essentials Antibody Sampler Kit。
保存条件
-20℃保存。自收到之日起一年内保持稳定。
背景介绍
铜死亡是一种新型的细胞死亡机制,由细胞内过量铜离子的积累引发。 这会促进脂肪分解异常和蛋白质聚集,导致氧化应激及线粒体活性受损。 铜死亡的关键调节蛋白包括 DLAT、FDX1 和 LIAS。 DLAT 作为丙酮酸脱氢酶复合体(PDC)的关键组成部分,是脂肪酰化和激活三羧酸循环中的酶所必需的。 在铜死亡过程中,铜含量的增加会导致脂肪酰化异常和DLAT聚集,从而发生线粒体功能障碍和细胞死亡。 合成硫辛酸所需的 LIAS 可保持TCA 循环酶(如 DLAT)的稳定和活性。 LIAS 功能的失调会导致脂酰化蛋白质病理性聚集,从而导致铜死亡。 FDX1 有助于调节细胞对铜诱导的应激反应。 它有助于还原铁硫(Fe-S)簇并参与调节铜离子平衡和氧化还原过程。 SLC31A1和DLD等其他蛋白质的失调也可能分别有助于增加铜的吸收及对铜死亡的敏感性。
标准实验流程
点击此处查看我们用于各种应用的标准流程,包括WB、IP、IHC、IF、FC和ELISA。